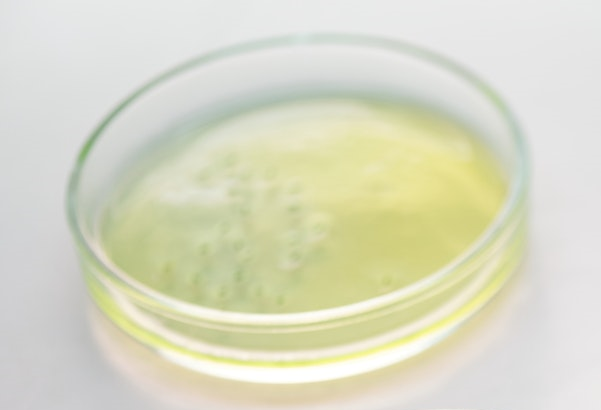

Niesamowity smak, któremu nikt nie może się oprzeć: Pyszny niewypiekany sernik czekoladowy.
Niesamowity przepis na bombastyczny niewypiekany sernikowo-czekoladowy tort, który zasmakuje każdemu. Ten sernik jest naprawdę łatwy w przygotowaniu i można go przygotować w kilka minut.

Składniki:
Spód:
- 250 g ciastek
- 150 g masła
Masa:
- 300 g mascarpone
- 100 ml mleka
- 150 g cukru
- 200 ml bitej śmietany
- 150 g gorzkiej czekolady
- 10 g żelatyny
- 100 ml wody
- 10 ml soku z cytryny
Przygotowanie:

Za pomocą miksera wymieszaj ciastka na drobny proszek i wrzuć je do większej miski. Dodaj roztopione masło i dobrze wymieszaj.

Tak przygotowaną masę przelać do tortownicy, lekko docisnąć na dnie łyżką. Wstaw do lodówki na 30 minut. Wykładamy krawędzie formy folią do ciasta.

W większej misce przygotować mascarpone, dodać cukier, mleko, sok z cytryny. Mieszaj, aż utworzy się gęsta piana. Następnie dodaj śmietankę i ponownie dobrze wymieszaj.

Dodaj trochę bitej śmietany do spęcznionej żelatyny. Wymieszaj łyżką. Następnie dodaj tę mieszankę do miski ze śmietaną i wymieszaj.
Część śmietanki wlej do mniejszej miski, następnie dodaj rozpuszczoną czekoladę i wymieszaj. Wlej śmietankę z większej miski do foremki na ciasto biszkoptowe.

